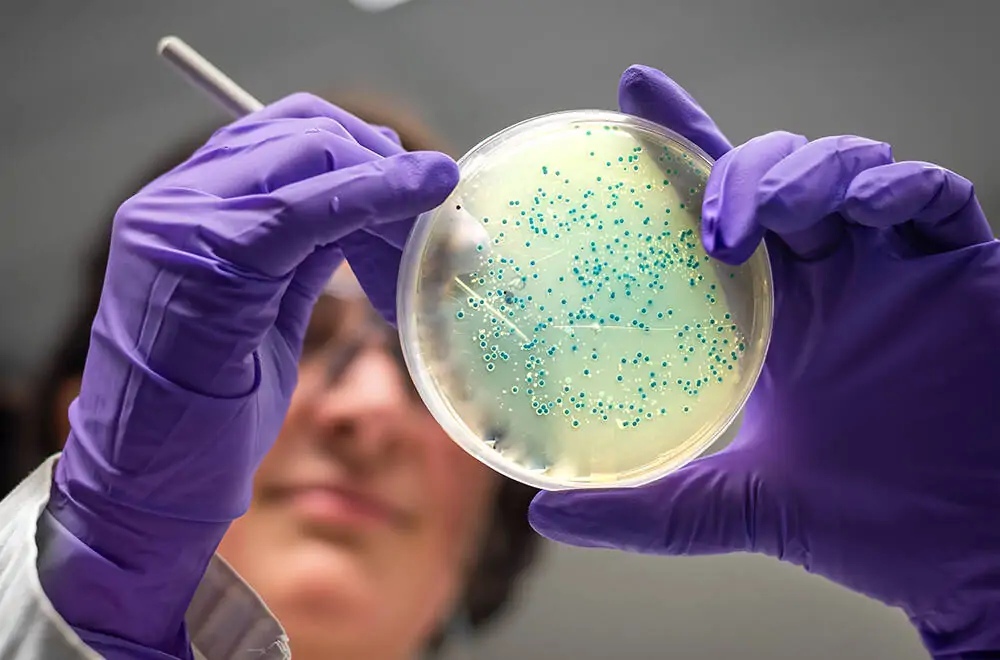

Скандалы, связанные с обнаружением опасных или запрещенных веществ в БАДах, происходят регулярно. Но самый свежий разгорается буквально сейчас, в ноябре 2025 года, и связан он с массовым заражением сальмонеллезом после приема популярных добавок. В Америке федеральные службы, FDA и CDC, уже объявили национальный отзыв1 - из продажи изымаются все партии "зеленого" суперфуда моринги, независимо от даты выпуска и срока годности.
Началось все с госпитализации пострадавших в нескольких штатах США. Анализы показали, что всех их объединяет одно - прием добавок “super green” с морингой. Экспертиза капсул подтвердила наличие в них бактерии Salmonella.
В настоящее время из оборота идет отзыв около 1,5 миллионов упаковок “Member’s Mark Super Greens Powder Supplements” от бренда Sam's Club. Однако расследование цепочек поставок (а в мире БАДов они бывают невероятно длинными) привело к первоисточнику - индийскому поставщику Vallon Farm Direct PVT LTD. Предполагается, что именно от этой компании поступило зараженное сырье.
Но ассортимент Vallon Farm Direct PVT LTD не ограничивается "засветившейся" морингой - компания является поставщиком около 100 видов органического сырья - семян, трав, подсластителей, муки и злаков - для производителей по всему миру. Это значит, что волна отзывов добавок с морингой коснется, вероятно, не только бренда Sam's Club. А риск заражения сальмонеллой вырастет не у одного вида БАДов, а у огромной категории органических “зеленых” добавок.
Волна паники пока не докатилась до России. Но означает ли это, что нам ничего не грозит? Можно ли быть уверенным, что купленная на российском маркетплейсе добавка с морингой действительно “чиста” и безопасна? И стоит ли сейчас вообще доверять всем “зеленым суперфудам” - или хотя бы временно воздержаться от их приема, чтобы не оказаться в числе тех, кого БАД уложил на больничную койку?
Что это вообще за моринга?
Моринга - одна из “звезд” здорового питания последних лет. Ее называют “деревом жизни”, пьют в капсулах и добавляют в смузи, чаи и порошки для “детокса”. Реклама называет морингу “настоящим суперфудом для тех, кто хочет улучшить свое здоровье и жизненную энергию”.
В карточках товара на маркетплейсах продавцы убеждают нас, что это мощный источник витаминов, минералов, белков и антиоксидантов, и приводят впечатляющие цифры:

Да, моринга, как, впрочем, и большинство зеленых растений, действительно содержит в своих листьях полезные активные вещества. И цифры из рекламы о том, что моринге в 7 раз больше витамина С, чем в апельсинах, или о том, что калия в 3 раза больше, чем в бананах, в общем-то верны, хотя и несколько преувеличены. Но - никто не уточняет, про какое количество “зеленого суперфуда” идет речь! Покупатель, очарованный впечатляющими цифрами, даже не догадывается, что для того, чтобы получить в “икс” раз больше витаминов и минералов, концентрированный порошок моринги придется есть черпаками - в рекламе речь идет о 100 граммах моринги (в некоторых случаях - и о 200гр).
Если же взять стандартную капсулу добавки “super green” (это обычно 500мг), то фактическая картина кардинально меняется:
Если принимать морингу по 4-8 капсул (как и советуют некоторые производители), то в целом она окажет положительное влияние на витаминный профиль. Но именно как часть общего рациона, а не как отдельный суперфуд.
Нутрициологов больше привлекают другие свойства моринги - экспериментальные данные2 (в пробирке, на клетках) показывают, что активные вещества в ее листьях могут снижать маркеры воспаления и окислительного стресса, улучшать показатели уровня глюкозы и артериального давления3, а также способствовать снижению “плохого” холестерина4.
Потенциальную пользу от приема моринги полностью нивелирует бактерия Salmonella, обнаруженная в индийском сырье. Но как подобное происходит?
Если же взять стандартную капсулу добавки “super green” (это обычно 500мг), то фактическая картина кардинально меняется:
- витамин С - в 1 капсуле моринги всего 1/100 (одна сотая) от того, что содержится в одном среднем апельсине
- витамин А - чтобы получить его столько же, сколько в одной средней моркови, придется принять около 60 капсул моринги за раз
- кальций - одна капсула моринги содержит примерно столько же кальция, сколько один глоток молока
- калий - чтобы получить калий, как в одном среднем банане, понадобится принять около 25 капсул моринги.
Если принимать морингу по 4-8 капсул (как и советуют некоторые производители), то в целом она окажет положительное влияние на витаминный профиль. Но именно как часть общего рациона, а не как отдельный суперфуд.
Нутрициологов больше привлекают другие свойства моринги - экспериментальные данные2 (в пробирке, на клетках) показывают, что активные вещества в ее листьях могут снижать маркеры воспаления и окислительного стресса, улучшать показатели уровня глюкозы и артериального давления3, а также способствовать снижению “плохого” холестерина4.
Потенциальную пользу от приема моринги полностью нивелирует бактерия Salmonella, обнаруженная в индийском сырье. Но как подобное происходит?
Как могло случиться заражение сырья для БАДов?
Сырье для моринги выращивают в теплых странах, где бактерии, вроде сальмонеллы, легко попадают на листья из почвы, воды для полива или с фекалиями птиц, грызунов или других животных, которые свободно гуляют по плантациям. Это, кстати, классическая “точка входа” для патогенов в растительную продукцию.
Сбор сырья вручную без соблюдения гигиены, использование грязного инструмента, складывание листвы на земле увеличивает риск заражения. К тому же, согласно исследованиям, уровень микробной нагрузки существенно выше у листьев, высушенных на открытом воздухе, чем у тех, что прошли камерную сушку (которая для Индии, например, не является распространенной практикой).
В высушенном сырье сальмонелла весьма неплохо существует, переходя в "спящее" состояние, - иногда месяцы и даже годы сохраняя инфекционность. И активируется уже в нашем организме.
Могут ли быть заражены другие “зеленые” добавки?
История с морингой - это только верхушка айсберга. Индийская компания Vallon Farm Direct PVT LTD, откуда и пришло зараженное сырье, - вовсе не маленькое фермерское хозяйство, а довольно крупный экспортер органических ингредиентов. На своем сайте они гордо называют себя “мостом между индийскими полями и мировыми брендами”, поставляя более ста видов растительного сырья. В ассортименте компании - не только моринга, но и цельнозерновая пшеница, семена киноа, эвкалипт, листья мяты, имбирь, лимонная цедра, базилик, порошки из ягод, зеленые смеси, а также злаки и мука. То есть все то, что сегодня активно продается в виде “суперфудов” и БАДов по всему миру - от США до Европы и России.
В случае с морингой было выяснено, что заражение бактериями сальмонеллы произошло не на финальном заводе-производителе, а именно на уровне сбора и обработки растительного сырья, в Индии. Предположение о том, что риск заражения может касаться не только моринги - вполне закономерно. Ведь достаточно одной непромытой мельницы - и следы сальмонеллы, попавшие с морингой, легко “пропутешествуют” к соседним партиям имбиря или куркумы.
А если заражено сырье, то оно может попасть в десятки разных добавок под разными брендами. Мы же с вами, конечные потребители, глядя на любую банку с капсулами или порошком, просто не видим, откуда могли приехать ингредиенты для производства биодобавок.
И даже если мы временно откажемся от покупки добавок индийских производителей, нет никакой гарантии, что другие изготовители БАДов, российские, белорусские или немецкие, не использовали в своей продукции сырье, зараженное сальмонеллой. Хотя, конечно, добросовестные производители обязаны проверять поступающие компоненты на наличие патогенов. На практике это происходит не всегда. И если на небрежности к проверке сырья “попался” такой довольно крупный бренд, как Sam's Club, то в дотошности мелких компаний или ИП тоже можно усомниться.

Как убедиться, что добавка “чиста”?
“На глаз” определить наличие сальмонеллы невозможно. Только лабораторные экспертизы (как сырья, так и на всех этапах поставок вплоть до конечного продукта) могут дать четкий и однозначный ответ.
По законодательству РФ все биологически активные добавки обязаны пройти санитарно-гигиенический контроль путем лабораторных испытаний образцов. Только после этой проверки, в том числе и на патогены, БАД получает свидетельство о госрегистрации (СГР). Убедиться в чистоте добавки может абсолютно бесплатно любой желающий - мы подробно рассказываем о том, как это сделать, здесь.

Если вернуться к добавкам, в составе которых есть моринга, то в Едином реестре СГР зарегистрировано только 8 БАДов! При учете, что в свободной продаже на маркетплейсах - сотни. Сотни добавок от разных производителей, размещенных в разделах “Парафармацевтика”, “Здоровье”, “Спорт и отдых” без всяких документов и, разумеется, проверок на сальмонеллу и другие возможные нарушения.

Но, к сожалению, мы вынуждены добавить, что и наличие СГР - не 100% гарантия чистоты и безопасности добавки. Система контроля устроена так, что получать СГР производителю (продавцу) нужно только перед выпуском БАДа в оборот. То есть один раз и на несколько лет. При этом совершенно упускаются из виду любые изменения в производстве или смена поставщиков сырья. Если действует СГР от 2016 года, то маловероятно, что за 9 лет у изготовителя не было никаких перемен. И прошедший контроль образец будет идентичен образцу 2025 года.
Возможное изменение с течением времени качества добавки, уже имеющей СГР, - “слабое место” системы. Но, по крайней мере, то, что производитель (продавец) озаботился получением необходимых документов и работает в соответствии с законодательством, уже снижает беспокойство о безопасности продукта.
Парадокс моринги
Семейство моринговых включает в себя 13 видов. Нас интересует Моринга масличная (Moringa oleifera) и Моринга овальнолистная (Moringa ovalifolia). Отличаются эти два вида и по составу, и по свойствам, и даже по внешнему виду:

Moringa oleifera (масличная) - вид, по которому есть определенная научная база и доказательства5 в ряде направлений (антиоксидантные и противовоспалительные эффекты, влияние на сахар и липиды, улучшение нутритивного статуса и так далее).
Moringa ovalifolia (овальнолистная) - вид, по которому исследований о полезных фармакологических свойствах практически нет.
Зачем нам знать эти отличия? А дело в том, что зараженные сальмонеллой добавки, из-за которых сейчас разгорается скандал, были изготовлены именно из моринги масличной. А вот все восемь добавок, зарегистрированных в российском государственном реестре и имеющих свидетельство о госрегистрации (СГР), содержат морингу овальнолистную - ту самую, чьи полезные свойства вызывают сомнения.
На маркетплейсах подавляющее большинство продающихся там порошков и капсул - из моринги масличной (по крайней мере, так указано на этикетках). На первый взгляд, неплохо - хоть и не панацея, как уверяет реклама, но за ней стоит хоть какая-то доказательная база. Но. В России моринга масличная запрещена для использования в составе БАД к пище - она числится под номером 313 в перечне растений, содержащих психотропные, сильнодействующие или ядовитые вещества.
Почему этот запрет действует - регуляторы не поясняют. Можно лишь предположить, что причина в недостаточной изученности метаболических эффектов моринги и данных о ее потенциальной гепатотоксичности (вреда для печени).
В итоге ситуация выглядит парадоксально: легальные БАДы - произведены из моринги без доказанной пользы, а “научно обоснованные” - запрещены. Поэтому для российского потребителя самый разумный и спокойный выбор сейчас - избегать добавок с морингой вообще: масличную - из-за запрета, овальнолистную - из-за отсутствия убедительных данных о пользе.
Что касается возможного заражения других “зеленых” суперфудов, то, при всех слабых местах системы контроля, наибольшую гарантию безопасности все же имеют продукты, имеющие Свидетельство о государственной регистрации (СГР), особенно если оно “свежее” - 2024 и 2025 года.
Будьте внимательны и проверяйте максимум доступной информации. А мы будем и дальше держать вас в курсе последних новостей и изменений на рынке БАДов.
Moringa ovalifolia (овальнолистная) - вид, по которому исследований о полезных фармакологических свойствах практически нет.
Зачем нам знать эти отличия? А дело в том, что зараженные сальмонеллой добавки, из-за которых сейчас разгорается скандал, были изготовлены именно из моринги масличной. А вот все восемь добавок, зарегистрированных в российском государственном реестре и имеющих свидетельство о госрегистрации (СГР), содержат морингу овальнолистную - ту самую, чьи полезные свойства вызывают сомнения.
На маркетплейсах подавляющее большинство продающихся там порошков и капсул - из моринги масличной (по крайней мере, так указано на этикетках). На первый взгляд, неплохо - хоть и не панацея, как уверяет реклама, но за ней стоит хоть какая-то доказательная база. Но. В России моринга масличная запрещена для использования в составе БАД к пище - она числится под номером 313 в перечне растений, содержащих психотропные, сильнодействующие или ядовитые вещества.
Почему этот запрет действует - регуляторы не поясняют. Можно лишь предположить, что причина в недостаточной изученности метаболических эффектов моринги и данных о ее потенциальной гепатотоксичности (вреда для печени).
В итоге ситуация выглядит парадоксально: легальные БАДы - произведены из моринги без доказанной пользы, а “научно обоснованные” - запрещены. Поэтому для российского потребителя самый разумный и спокойный выбор сейчас - избегать добавок с морингой вообще: масличную - из-за запрета, овальнолистную - из-за отсутствия убедительных данных о пользе.
Что касается возможного заражения других “зеленых” суперфудов, то, при всех слабых местах системы контроля, наибольшую гарантию безопасности все же имеют продукты, имеющие Свидетельство о государственной регистрации (СГР), особенно если оно “свежее” - 2024 и 2025 года.
Будьте внимательны и проверяйте максимум доступной информации. А мы будем и дальше держать вас в курсе последних новостей и изменений на рынке БАДов.
Хотите обсудить эту статью с экспертами и другими читателями? Ссылка на пост по данной статье, где вы можете задать вопросы по статье или оставить свои комментарии.
Поддерживайте нашу работу подпиской на наши соцсети и лайками, присоединяйтесь к нашему Telegram-каналу, где вы найдете свежие новости проекта, последние результаты проверок, а также разбор и обсуждение их с экспертами, делитесь информацией о проекте “Не рискуй. Проверь!” с вашими друзьями и близкими, ведь мы трудимся для того, чтобы вы были уверены в качестве добавки, которую покупаете.
Поддерживайте нашу работу подпиской на наши соцсети и лайками, присоединяйтесь к нашему Telegram-каналу, где вы найдете свежие новости проекта, последние результаты проверок, а также разбор и обсуждение их с экспертами, делитесь информацией о проекте “Не рискуй. Проверь!” с вашими друзьями и близкими, ведь мы трудимся для того, чтобы вы были уверены в качестве добавки, которую покупаете.
Проект "Не рискуй. Проверь" не занимается рекламой или продажей БАДов. Упомянутые в статье препараты приведены исключительно в качестве примеров и не являются рекомендацией к их приобретению.
1 FDA: Расследование вспышки сальмонеллеза: порошок из листьев моринги
2 MDPI: Антиоксидантная, противовоспалительная активность и биодоступность этанольных экстрактов из листьев мексиканской моринги масличной (Moringa oleifera) in vitro
3 Asian Pacific Journal of Tropical Biomedicine: Терапевтический потенциал Moringa oleifera Lam. при метаболических нарушениях: молекулярный обзор
4 MDPI: Изучение фитохимических, фармакологических и питательных свойств Moringa oleifera : комплексный обзор
5 PMC: Moringa oleifera : обновленный комплексный обзор ее фармакологической активности, этномедицинских, фитофармацевтических свойств, клинических, фитохимических и токсикологических аспектов
2 MDPI: Антиоксидантная, противовоспалительная активность и биодоступность этанольных экстрактов из листьев мексиканской моринги масличной (Moringa oleifera) in vitro
3 Asian Pacific Journal of Tropical Biomedicine: Терапевтический потенциал Moringa oleifera Lam. при метаболических нарушениях: молекулярный обзор
4 MDPI: Изучение фитохимических, фармакологических и питательных свойств Moringa oleifera : комплексный обзор
5 PMC: Moringa oleifera : обновленный комплексный обзор ее фармакологической активности, этномедицинских, фитофармацевтических свойств, клинических, фитохимических и токсикологических аспектов

